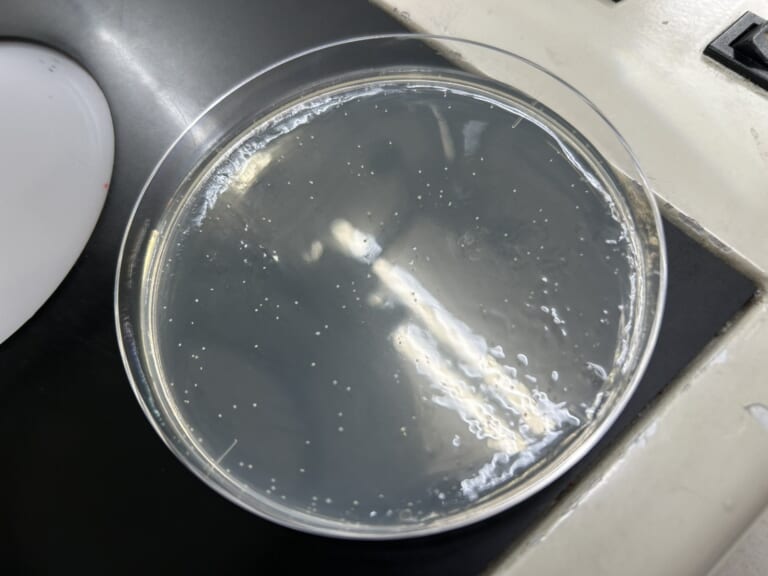
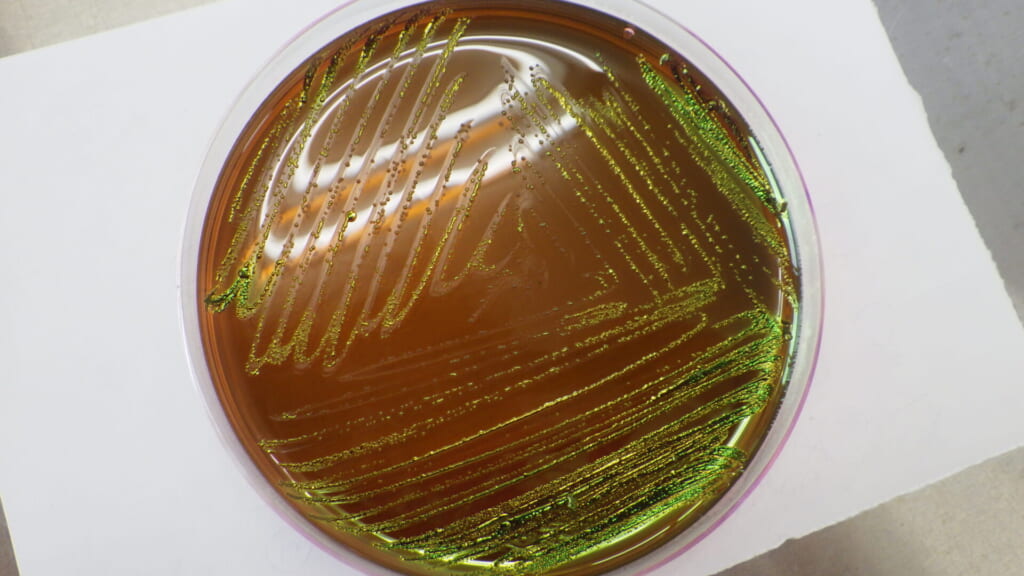

大阪王将の冷凍食品の安心・安全を守る上で欠かせない、イートアンド工場の検査室業務のご紹介をいたします。
前編では微生物検査についてご紹介します。
微生物検査ってなに?
ここでいう微生物検査とは、食品の安全性や食中毒の原因となる微生物の有無、衛生状態を確認するために菌数を調べることです。食品が腐ったり、それを食べてしまってお腹を壊したりする大部分は、微生物が原因となって起こります。お客様が安全に安心して食べられるよう定期的に検査をし、合格したものだけがお店に並びます。
イートアンドでは、検査用にサンプリングされた製品の一般生菌数、大腸菌群・大腸菌、黄色ブドウ球菌、サルモネラ菌などの検査をして安全性の確認をしております。

一般生菌数検査
一般生菌数検査は、食品の「微生物汚染の程度」を評価するための指標となる検査です。
“一般生菌数”とは、34~36℃の条件で48時間培養後、標準寒天培地に発育した集落数(コロニー)を計測して出される数値のことです。計測値はCFU/g(またはmL)で示され、結果は食品の衛生的な取り扱いの状態や製造・加工環境の汚染状況を評価するのに有効です。
大腸菌群・大腸菌検査
大腸菌群検査は、食品の加熱の適正性や加熱後の二次汚染、および衛生管理状態を評価するための指標となる検査です。
“大腸菌群”とはグラム陰性で無芽胞性の乳糖分解菌の総称であり、その中の一種である大腸菌(E. coli)や腸管系病原菌の有無を推測する目的でも利用されます。冷凍食品では、凍結工程前に加熱する食品では検出されるべきではないとされ、検出された場合は加熱不足や不衛生な取り扱いが疑われます。
黄色ブドウ球菌検査
黄色ブドウ球菌とはその名の通り、ぶどうの房のような見た目をしているグラム陽性球菌です。
健康な人間の皮膚にも存在するとても身近な菌です。これが食べ物の中で増殖するときにエンテロトキシンという毒素をつくり、この毒素を食品と一緒に食べることにより、食中毒になってしまいます。菌自体は熱に弱いのですが、一度つくられた毒素は100℃20分の加熱にも耐えられるため、「黄色ブドウ球菌を付けない・増殖させない」ことが食中毒を予防するポイントとなります。
イートアンドの製品検査では、選択培地を用いてこの黄色ブドウ球菌が食品中に存在するか否かを確認しております。
サルモネラ菌検査
サルモネラ菌は鶏・豚・牛等の動物の腸管や河川・下水道等の自然界に広く生息する細菌で、少量の菌数でも食中毒を引き起こす場合があります。
感染していても症状が出ないこともあり、自覚症状の無い感染したヒトから調理器具などを介して食品に付着(二次汚染といいます)、その食品を食べることでさらに感染者を増やしてしまう可能性もあります。
サルモネラ菌も黄色ブドウ球菌と同様に、選択培地を用いて食品中に存在するか否か判定する製品検査を実施しております。
また、イートアンドの工場では月に一度検便検査を実施しております。
まとめ
いかがでしたか?
イートアンドの検査室では、有害な微生物が入らず、お客様に安心して食べていただけるように日々検査をしています。
これからも安全第一に検査を実施してまいります!

後編では、微生物検査以外の検査室の役割をご紹介します。お楽しみに!